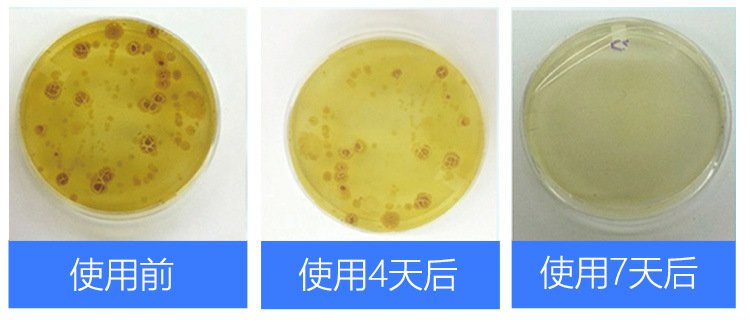

Япония импортировал бассейн мочи SANADA Удаление шарикового ароматического ароматического аромата, дезодорант -блок -треугольник Блок мочи ведро

Цена: 155руб. (¥7.3)
Артикул: 576062263838
Доставка по Китаю (НЕ включена в цену):
106 руб. (¥5)
Вес товара: ~0.7 кг. Указан усредненный вес, который может отличаться от фактического. Не включен в цену, оплачивается при получении.
Описание товараPGRpdj48aW1nIHNyYz0iaHR0cHM6Ly9pbWcuYWxpY2RuLmNvbS9pbWdleHRyYS9pMi8xNjc2ODU2ODY1L08xQ04wMVA4MDF5NTIwYURlR1lVVFJuXyEhMTY3Njg1Njg2NS5wbmciPjwvZGl2PjxkaXY+PGltZyBzcmM9Imh0dHBzOi8vaW1nLmFsaWNkbi5jb20vaW1nZXh0cmEvaTQvMTY3Njg1Njg2NS9PMUNOMDFKSTduNkkyMGFEZHZ1RWQ1NF8hITE2NzY4NTY4NjUuanBnIj48L2Rpdj48ZGl2PjxpbWcgc3JjPSJodHRwczovL2ltZy5hbGljZG4uY29tL2ltZ2V4dHJhL2kzLzE2NzY4NTY4NjUvVEIyZkpUZHFXUW9CS05qU1pKblhYYXc5VlhhXyEhMTY3Njg1Njg2NS5wbmciPjwvZGl2PjxkaXY+PGltZyBzcmM9Imh0dHBzOi8vaW1nLmFsaWNkbi5jb20vaW1nZXh0cmEvaTIvMTY3Njg1Njg2NS9UQjJTLlJZclhrb0JLTmpTWkZrWFhiNHRGWGFfISExNjc2ODU2ODY1LnBuZyI+PC9kaXY+PGRpdj48aW1nIHNyYz0iaHR0cHM6Ly9pbWcuYWxpY2RuLmNvbS9pbWdleHRyYS9pMS8xNjc2ODU2ODY1L1RCMlZyMWFybHNtQktOalNaRnNYWGFYU1ZYYV8hITE2NzY4NTY4NjUucG5nIj48L2Rpdj48ZGl2PjxpbWcgc3JjPSJodHRwczovL2ltZy5hbGljZG4uY29tL2ltZ2V4dHJhL2kzLzE2NzY4NTY4NjUvVEIyUWNfT3E5TW1CS05qU1pURVhYYXNLcFhhXyEhMTY3Njg1Njg2NS5wbmciPjwvZGl2PjxkaXY+PGltZyBzcmM9Imh0dHBzOi8vaW1nLmFsaWNkbi5jb20vaW1nZXh0cmEvaTMvMTY3Njg1Njg2NS9UQjJhaGVlcmlBbkJLTmpTWkZ2WFhhVEtYWGFfISExNjc2ODU2ODY1LnBuZyI+PC9kaXY+PGRpdj48aW1nIHNyYz0iaHR0cHM6Ly9pbWcuYWxpY2RuLmNvbS9pbWdleHRyYS9pMS8xNjc2ODU2ODY1L1RCMm84S1JyYnNyQktOalNaRnBYWGNYaEZYYV8hITE2NzY4NTY4NjUucG5nIj48L2Rpdj48ZGl2PjxpbWcgc3JjPSJodHRwczovL2ltZy5hbGljZG4uY29tL2ltZ2V4dHJhL2kxLzE2NzY4NTY4NjUvVEIyRHc5Q3JsalRCS05qU1pGdVhYYjBIRlhhXyEhMTY3Njg1Njg2NS5wbmciPjwvZGl2PjxkaXY+PGltZyBzcmM9Imh0dHBzOi8vaW1nLmFsaWNkbi5jb20vaW1nZXh0cmEvaTIvMTY3Njg1Njg2NS9UQjI4VE9YcmxqVEJLTmpTWkZ3WFhjRzRYWGFfISExNjc2ODU2ODY1LnBuZyI+PC9kaXY+PGRpdj48aW1nIHNyYz0iaHR0cHM6Ly9pbWcuYWxpY2RuLmNvbS9pbWdleHRyYS9pNC8xNjc2ODU2ODY1L1RCMnRWWFpyWGtvQktOalNaRmtYWGI0dEZYYV8hITE2NzY4NTY4NjUucG5nIj48L2Rpdj48ZGl2PjxpbWcgc3JjPSJodHRwczovL2ltZy5hbGljZG4uY29tL2ltZ2V4dHJhL2kyLzE2NzY4NTY4NjUvVEIyNHV6b3Ewa25CS05qU1pLUFhYWDZPRlhhXyEhMTY3Njg1Njg2NS5wbmciPjwvZGl2PjxkaXY+PGltZyBzcmM9Imh0dHBzOi8vaW1nLmFsaWNkbi5jb20vaW1nZXh0cmEvaTIvMTY3Njg1Njg2NS9UQjJFZkYycmxzbUJLTmpTWkZGWFhjVDlWWGFfISExNjc2ODU2ODY1LnBuZyI+PC9kaXY+PGRpdj48aW1nIHNyYz0iaHR0cHM6Ly9pbWcuYWxpY2RuLmNvbS9pbWdleHRyYS9pMy8xNjc2ODU2ODY1L1RCMk9PNTZxV0FvQktOalNaU3lYWGFIQVZYYV8hITE2NzY4NTY4NjUucG5nIj48L2Rpdj48ZGl2PjxpbWcgc3JjPSJodHRwczovL2ltZy5hbGljZG4uY29tL2ltZ2V4dHJhL2kyLzE2NzY4NTY4NjUvVEIyV1hoWnJYa29CS05qU1pGa1hYYjR0RlhhXyEhMTY3Njg1Njg2NS5wbmciPjwvZGl2PjxkaXY+PGltZyBzcmM9Imh0dHBzOi8vaW1nLmFsaWNkbi5jb20vaW1nZXh0cmEvaTQvMTY3Njg1Njg2NS9UQjJSTnllcmlBbkJLTmpTWkZ2WFhhVEtYWGFfISExNjc2ODU2ODY1LnBuZyI+PC9kaXY+PGRpdj48aW1nIHNyYz0iaHR0cHM6Ly9pbWcuYWxpY2RuLmNvbS9pbWdleHRyYS9pMi8xNjc2ODU2ODY1L1RCMnF6YUlxWklyQktOalNaSzlYWGFnb1ZYYV8hITE2NzY4NTY4NjUucG5nIj48L2Rpdj48ZGl2PjxpbWcgc3JjPSJodHRwczovL2ltZy5hbGljZG4uY29tL2ltZ2V4dHJhL2kyLzE2NzY4NTY4NjUvVEIyLklYX3JiWm5CS05qU1pGS1hYY0dPVlhhXyEhMTY3Njg1Njg2NS5wbmciPjwvZGl2PjxkaXY+PGltZyBzcmM9Imh0dHBzOi8vaW1nLmFsaWNkbi5jb20vaW1nZXh0cmEvaTQvMTY3Njg1Njg2NS9UQjJ0NmlocmJabkJLTmpTWkZyWFhhUkxGWGFfISExNjc2ODU2ODY1LnBuZyI+PC9kaXY+PGRpdj48aW1nIHNyYz0iaHR0cHM6Ly9pbWcuYWxpY2RuLmNvbS9pbWdleHRyYS9pMi8xNjc2ODU2ODY1L1RCMmhRTHJxVm9vQktOalNaUGhYWGMyQ1hYYV8hITE2NzY4NTY4NjUucG5nIj48L2Rpdj48ZGl2PjxpbWcgc3JjPSJodHRwczovL2ltZy5hbGljZG4uY29tL2ltZ2V4dHJhL2kyLzE2NzY4NTY4NjUvVEIyNEhldXJiWm5CS05qU1pGaFhYYy5vWFhhXyEhMTY3Njg1Njg2NS5wbmciPjwvZGl2PjxkaXY+PGltZyBzcmM9Imh0dHBzOi8vaW1nLmFsaWNkbi5jb20vaW1nZXh0cmEvaTQvMTY3Njg1Njg2NS9UQjJrWWl1cmJabkJLTmpTWkZoWFhjLm9YWGFfISExNjc2ODU2ODY1LnBuZyI+PC9kaXY+
Продавец:日本百元店
Рейтинг:

Всего отзывов:0
Положительных:0
Добавить в корзину
- Информация о товаре
- Фотографии